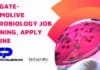
Colgate-Palmolive Microbiology Job Opening, Apply Online Colgate-Palmolive Microbiology Job

Gut Bacteria Could be the Key to Understanding Diabetes and Obesity
Doctors in India and Denmark are collecting samples of stool from about 900 people in both countries, extracting DNA from it and studying it...
GM Mustard Hybrid Accused of being Plagued with Technical Flaws
Even after Genetic Engineering Approval Committee (GEAC) of the Union ministry of environment, forests and climate change has put the commercialization of genetically modified...
Multitasking: Some Bacterial CRISPRs Can also Snip RNA
Stories about the highly lauded, much-discussed genome editing system CRISPR/Cas9 are floating around by the dozens. But little is it known that the system...
Chance of a Cure: Cancer’s Weak Spot Discovered by British Scientists
A major British discovery is expected to lead to revolutionary bespoke treatments for patients with advanced cancer that could enter trials within two years....
R&D Openings @ National Agri-Food Biotechnology Institute (NABI)
National Agri-Food Biotechnology Institute (NABI), Mohali is an autonomous R&D Institute under Department of Biotechnology (DBT), Government of India. The institute carries out cutting...
Apply for Research Fellow post @ IVRI – Experience in ELISA, HPLC and GLC...
Established in 1889, the Indian Veterinary Research Institute (IVRI) is one of the premier research institutions dedicated to livestock research and development of the...
IIT Bhubaneswar invites application for admission to Ph.D. Programme
Indian Institute of Technology Bhubaneswar is an engineering and technology higher education institute, located at Bhubaneswar, Odisha, India. It is one of the eight...
SRF posts vacant at Multiple location of – National Bureau of Fish Genetic Resources
The National Bureau of Fish Genetic Resources (NBFGR) was established in 1983 and has emerged as a Center of Excellence in cataloguing and conserving...
Grab opportunity to work in Upstream Process Development for Biologics !
Aurobindo Pharma Ltd (APL). APL is a growing Indian multinational pharmaceutical manufacturing firm with turnover of over US$650Mn, with presence in more than 22...
Microbiology Officer Post Vacant @ Lupin
Lupin Limited is one of India's largest manufacturers of bulk actives and formulations. The principal bulk actives manufactured by it include Rifampicin, Pyrazinamide, Ethambutol...
Earn Upto Rs 6 lakh as Microbiology Associates @ Liva Pharma – Zydus Group...
Liva Pharmaceuticals Limited - a Zydus Group of company is setting up a state-of-art injectable products manufacturing facility at Vadodara (Village : Jarod, Halol...
Openings in Biologics R&D Division @ Aurobindo Pharma ,Hyderabad
Aurobindo Pharma Ltd (APL). APL is a growing Indian multinational pharmaceutical manufacturing firm with turnover of over US$650Mn, with presence in more than 22...
6 Openings in Cell Line Development R&D @ AUROBINDO PHARMA LTD (APL)
Aurobindo Pharma Ltd (APL). APL is a growing Indian multinational pharmaceutical manufacturing firm with turnover of over US$650Mn, with presence in more than 22...
Zika – The Deadliest Virus or an Experiment Gone Wrong ?
Issue Description
The unchecked spread of virus created a situation of panic in major parts of the globe to an extent of a "Global health...
Work in Purification Sciences – Downstream Process Development Biologics R&D @ APL
Aurobindo Pharma Ltd (APL). APL is a growing Indian multinational pharmaceutical manufacturing firm with turnover of over US$650Mn, with presence in more than 22...